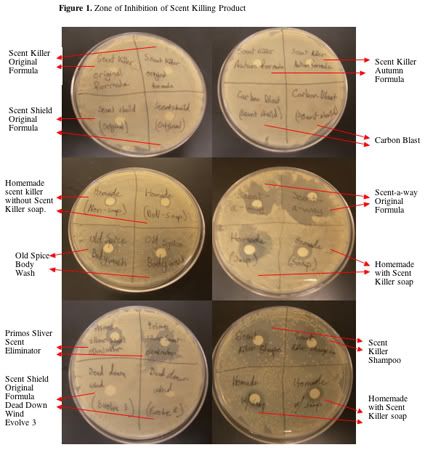

Homemade Scent Killer Spray
Homemade scent killer spray. Pour this mixture into a. To prepare the blend put the water and hydrogen peroxide on a large bowl afterwards add baking soda gently without shaking just stir slowly with a plastic spoon until the baking soda dissolves. Id have to use about 2 gallons of the stuff yikes.
Easycheap homemade scent killer. Anyone else have a home recipe that works. Man the stuff on the shelves is sure expensive if you use as much as they suggest.
It could also be used for hunting Deer and Co. Follow the tips below to make a homemade bee repellent spray. I found this from qdma.
What you will need. Pure distilled water rainwater works well as well. 1 ¾ cups distilled water.
Mix Gently combine all the ingredients in a large bowl until the baking soda dissolves. I know Harvey Lee has a recipe that maybe hell share. Materials we will need to make our homemade cover scents for deer and hog hunting are.
Not tap water as it has chlorine and other chemicals in it. It seemed to work well for me just as good as the commercial overpriced stuff. Im leaving in a week for a 9 day hunt.
This video shows how to make the homemade DIY scent killer spray we used in a pinch during our Texas hog hunt. The ingredients may fizz a little so wait a few minutes until they stop fizzing.
He then adds 2 cups of 3 percent peroxide that you can find at a pool supply.
They cant stand it and will do all they can to get away from it. Im leaving in a week for a 9 day hunt. Shop Assemble the ingredients. This video shows how to make the homemade DIY scent killer spray we used in a pinch during our Texas hog hunt. The smell of peppermint oil and cinnamon is something bees and wasps hate. Pure distilled water rainwater works well as well. 1 ¾ cups distilled water. Anyone else have a home recipe that works. Make a fresh batch each time you use it.
Mix Gently combine all the ingredients in a large bowl until the baking soda dissolves. 1 tablespoon of lemon juice store bought or fresh squeezed Mix water baking soda and lemon juice in a large bowl and stir or whisk together. All you need for mixing your own homebrew scent control spray is some peroxide 3 distilled water baking soda and a tiny bit of unscented soap. Id have to use about 2 gallons of the stuff yikes. Craig starts with a gallon bottle and 16 ounces 2 cups of distilled water. Follow the tips below to make a homemade bee repellent spray. Not tap water as it has chlorine and other chemicals in it.

Post a Comment for "Homemade Scent Killer Spray"